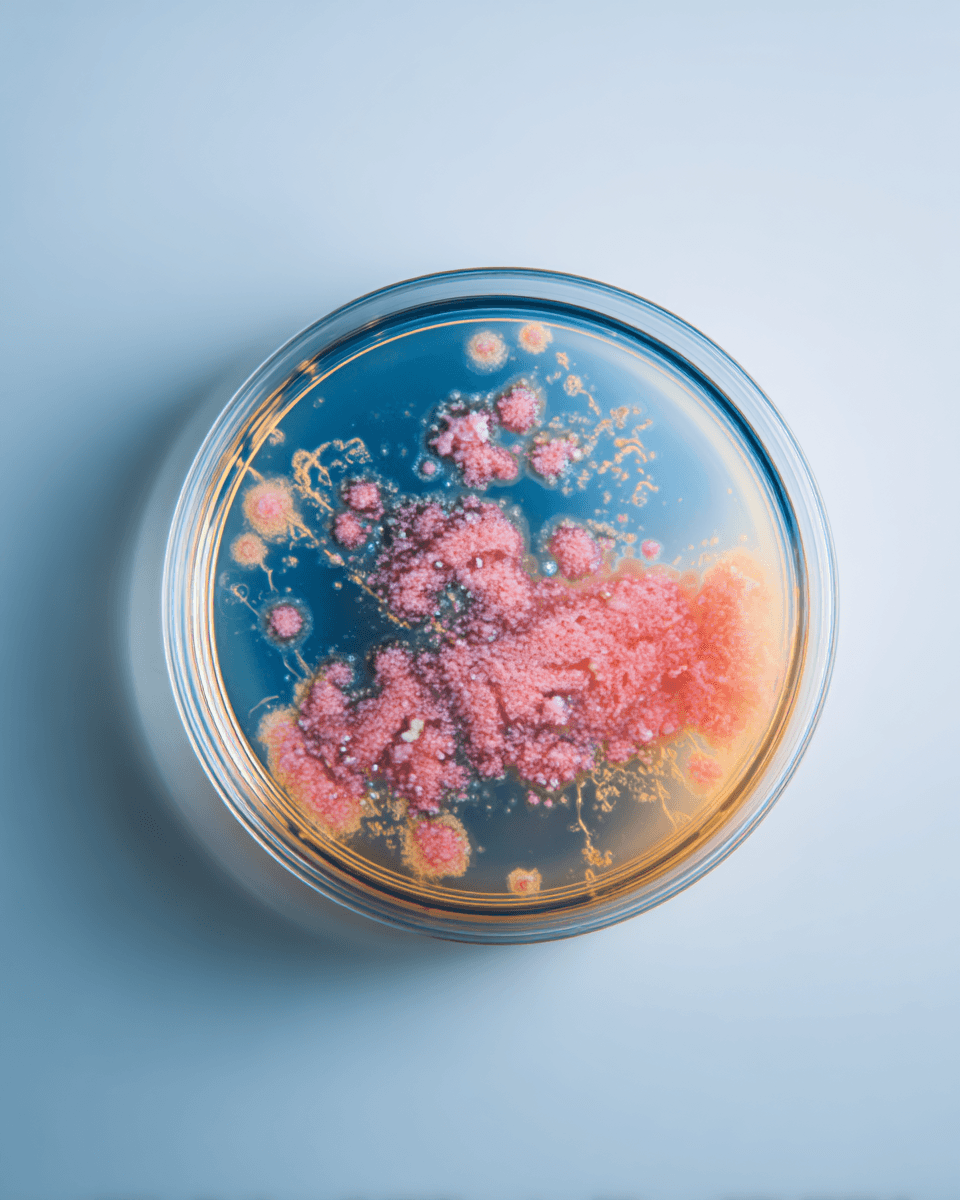
Immune Support

Biohax — Structured Supplementation
One daily pod.
Three precision
paths.
Biohax uses biomarkers, formula architecture, and Epigenetic Enhancement Therapy™ to structure supplementation around your biology — delivered in one daily granule pod, every 28 days.
Compare the 3 paths
Three ways to start Biohax
One daily pod. One system. Choose the path that fits where you are, then explore the product page that matches your level of personalization.

Goal-based formulas
Core Precision Formulas
Goal-based formulas
Start with a structured formula path
Choose from 20 precision formulas organized across 5 biological systems. One formula per 28-day cycle. The clearest way to begin a structured supplementation system without building from scratch.
Best for
People who want a simple, goal-focused entry into Biohax with one targeted formula per cycle.
One targeted formula per 28-day cycle
Choose from 20 precision formulas
Structured daily pod delivery
Clear biological goal orientation
Allergen Notice: All Biohax formulas contain ingredients processed with gluten, milk, and soy. Please review formula-specific ingredient and caution details before purchasing.
The Biohax standard
You don't guess.
You run systems.
One daily input. Consistent for 28 days. Built to compound over time.
Biohax is a structured supplementation system — biomarker-guided, epigenetically informed, and built around the kind of consistency that actually changes biology.
0
precision formulas
0
day cycle cadence
0
precision paths
How it works
From checkout to long-term refinement.
Biohax is not a shipment. It is a guided system — one daily pod, a portal to manage your protocol, and refinement that evolves with your biology.
Choose your path
Select Core Precision Formulas, Custom Pod Builder, or EET™ Guided Pod — the most personalized option, built from your biomarkers.
Complete checkout
Purchase directly on the Biohax website. Your first 28-day protocol is prepared and your portal account is created.
Receive your pod
Your daily pod ships and login credentials arrive by email. Everything you need to begin arrives together.
Access your dashboard
Log in to track your goals, view your active protocol, manage your order, and monitor progress cycle by cycle.
Refine over time
EET™ Guided users receive quarterly biomarker-driven refinements. Core and Custom users run structured 28-day protocols continuously.
Choose your path
Select Core Precision Formulas, Custom Pod Builder, or EET™ Guided Pod — the most personalized option, built from your biomarkers.
Complete checkout
Purchase directly on the Biohax website. Your first 28-day protocol is prepared and your portal account is created.
Receive your pod
Your daily pod ships and login credentials arrive by email. Everything you need to begin arrives together.
Access your dashboard
Log in to track your goals, view your active protocol, manage your order, and monitor progress cycle by cycle.
Refine over time
EET™ Guided users receive quarterly biomarker-driven refinements. Core and Custom users run structured 28-day protocols continuously.
Portal access is included with every Biohax path — your dashboard, protocol, and progress all in one place.
The cadence
Optimization happens in cycles
Biohax runs on 28-day cycles. Each one builds on the last. Bloodwork drives quarterly refinements — protocols sharpen with every pass.
Blood exam kit ships
Protocol begins
Your intake questionnaire is reviewed and your first 28-day protocol is dispatched. Your at-home blood exam kit ships with your first order. Return bloodwork within your first cycle to initiate your first data-driven refinement.
Bloodwork analyzed
Biology responds
Your protocol runs continuously while the Biohax clinical team analyzes your bloodwork. Consistent daily support allows your biology to establish a measurable baseline. Epigenetic adaptations typically require 4–8 months of structured supplementation to register.
Protocol refined
Quarterly refinement
Your protocol updates based on your latest biomarker data. Each refinement cycle deepens precision. Bloodwork submitted on schedule drives your next protocol change — if results are delayed, your current formula continues until updated data is available.
Blood exam kit ships
Month 1
Protocol begins
Your intake questionnaire is reviewed and your first 28-day protocol is dispatched. Your at-home blood exam kit ships with your first order. Return bloodwork within your first cycle to initiate your first data-driven refinement.
Epigenetic adaptations require time. Consistent cycles — with bloodwork returned on schedule — are the foundation of measurable, lasting change.
The problem
Complexity is the enemy of consistency.
The average supplement routine requires 4–7 bottles and up to 20 capsules daily. Most people quit within 90 days. Not from lack of intent — because the system creates too much friction to actually maintain.
Too many bottles — The average routine requires 4–7 separate products.
Too many capsules — Up to 20+ pills daily — impossible to sustain long-term.
Generic dosing — One-size formulas that ignore what your biology actually needs.
No structural logic — Ingredients that compete or cancel each other out.
The Biohax approach
One structured daily pod.
Precision micro-granule dosing.
A consistent 28-day cadence.
Typical routine

Multiple bottles · Multiple pills · No system.
Biohax pod

One daily action · Nothing extra to manage.
The formula system
20 Core Precision Formulas
Organized across 5 biological systems. Each formula is designed for one targeted goal — one formula per 28-day cycle on the Core path. Simple by design.
Core Precision path: one formula per 28-day cycle. Custom Pod Builder and EET™ Guided Pod offer multi-formula configurations tailored to your protocol.
Standards
Built to a standard worth holding.
Third-party tested
Every batch tested for purity, potency, and contaminants before it ships. Traceability is non-negotiable.
Bioavailable formulas
Structured dosing logic, bioavailable nutrient forms, and formula synergies built for actual effectiveness.
28-day cycle
One pod daily. A structured monthly cadence designed for the kind of consistency that compounds.
Adjust anytime
Refine your formula selection or change your path each cycle. Cancel without friction, anytime.
Important Disclaimer: These statements have not been evaluated by the Food and Drug Administration. This product is not intended to diagnose, treat, cure, or prevent any disease. Individual results may vary. Consult a qualified healthcare professional before starting any new supplement regimen.
Common questions
FAQ
What is a "pod" and how is it different from pills?
A pod is a single, structured daily dose containing micro-granules (mini-doses) of the nutrients in your formula. It is significantly smaller than traditional supplement bottles and eliminates pill fatigue. The pod delivers precision dosing in one daily action.
Do I need epigenetic testing to use Biohax?
No. Testing is optional. You can choose from 20 precision formulas or build a custom pod without any testing. Epigenetic testing (EET™ Guided path) enables deeper personalization but is not required to benefit from Biohax.
Are these subscriptions? Can I cancel?
Yes, all plans are monthly subscriptions that auto-renew. You can cancel anytime with no long-term obligation. Subscriptions deliver a 4-week supply of your selected precision path each month.
Can I customize my pod after I purchase?
Yes. After purchase, you can configure your pod inside the Biohax platform. Core Precision users select from 20 formulas. Custom Pod Builder users can stack multiple formulas or manually select individual nutrients. EET™ Guided users receive data-driven formulations based on their test results.
Begin your first cycle
Start running your biology like a system.
Choose your path and begin your first 28-day protocol.